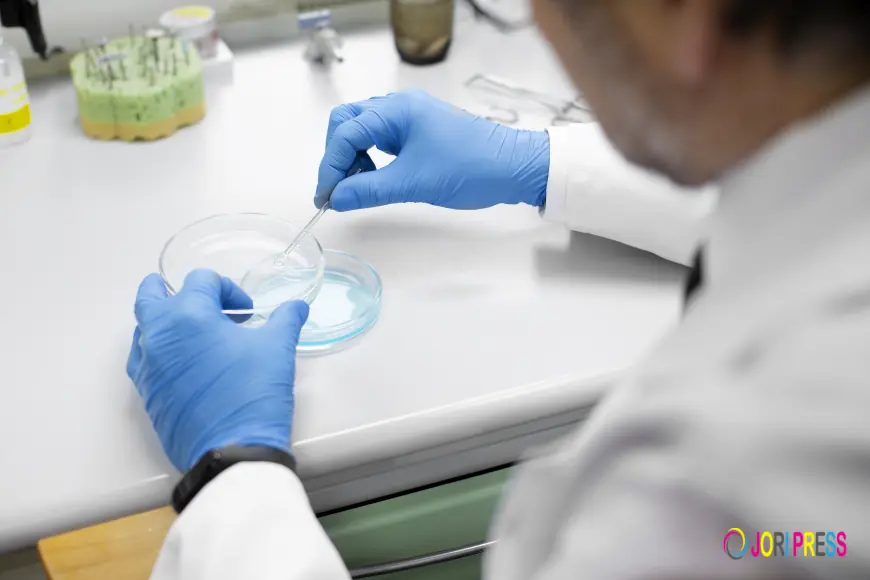
PDEU Biotechnology Students Explore Real - World Laboratory Operations at Accumax

PDEU Biotechnology Students Explore Real - World Laboratory Operations at Accumax
PDEU biotechnology students explore Accumax’s world-class lab manufacturing, R&D, and quality processes during an insightful industrial visit.
Accumax Lab Devices Pvt. Ltd. hosted an enriching industrial tour for more than 75 biotechnology students along with their faculty members from Pandit Deendayal Energy University (PDEU), Ahmedabad, on 2nd September, 2025. The visit was designed to help students see how a contemporary laboratory equipment manufacturer functions, going beyond textbooks and lectures.
Giving students an up-close look at the industrial process, from product design to worldwide distribution, was a straightforward yet a powerful start to an idea. It was also a great opportunity for accumaxlab, a global leader in benchtop lab equipment and liquid handling consumables, to demonstrate how its innovations contribute to the advancement of biotechnology, research, and diagnostics globally.
A Warm Start
The day began with a warm welcome over coffee and tea. Following students were introduced to Accumax’s journey and vision with a short corporate presentation along with product demonstration. This set the stage for what was to come next, as many were surprised to learn how widely pipettes, cryovials, and benchtop instruments were used across healthcare, research and even vaccine development.
Inside The Facilities
The students first visited the Accumax manufacturing plant (Gandhinagar), where they saw assembly lines for pipettes and liquid handling, ISO-compliant cleanrooms for making tubes, tips, and cryovials, and the last phases of sterile packaging and quality control. They were also better able to relate how a product created here eventually makes its way to labs around the world after witnessing the scope of global logistics.
They then proceeded to the innovative R&D and Design Labs. Here, students saw firsthand how devices such as centrifuges, stirrers,and vortex mixers are designed, built, tested, and shipped.
Lastly, students had the opportunity to interact with the instruments themselves in the Product Interaction Corner. The group was able to see firsthand how these tools facilitate experiments and industrial applications in the real world through live demonstrations, even though not everyone was able to participate in hands-on activities.
Learning Beyond The Classroom
The ability to translate theory into practice was the main lesson learned by many students. Suddenly, things that had only been discussed in lectures—like cleanrooms, quality checks, and R&D setups—became tangible and real. The visit also demonstrated how crucial accuracy, security, and creativity are to creating dependable laboratory products.
In response, Accumax underlined that it is still available to colleges and other organizations that wish to give their students comparable exposure, thereby enhancing the connection between academia and business.
Closing on a High Note
The visit ended on a warm note with a group photograph, vote of thanks, and lunch. Faculty members expressed appreciation for the effort put in by the Accumax team to make the day engaging and educational, while students left with a new sense of curiosity about their future careers.
Conclusion
Such visits do more than showcase manufacturing—they inspire. By hosting the PDEU Biotechnology department, Accumax once again underlined its commitment to innovation, education, and collaboration with academia.
“It was a pleasure to host students from PDEU who were eager to explore real-world laboratory practices. The exchange of ideas and exposure beyond the classroom made it a meaningful experience for all. At Accumax, we believe in creating more such opportunities that help nurture the next generation of scientists and innovators.
What's Your Reaction?
 Like
0
Like
0
 Dislike
0
Dislike
0
 Love
0
Love
0
 Funny
0
Funny
0
 Angry
0
Angry
0
 Sad
0
Sad
0
 Wow
0
Wow
0
















































